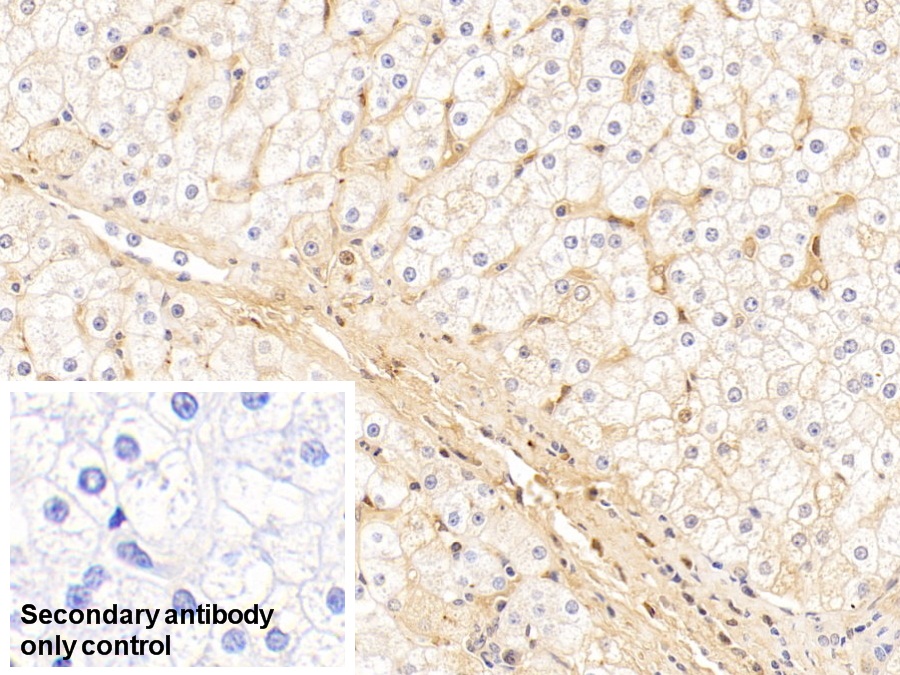

Polyclonal Antibody to Immunoglobulin A (IgA) 

Overview
Properties
- Product No.PAA546Hu05
- Organism SpeciesHomo sapiens (Human) Same name, Different species.
- ApplicationsWB; IHC
If the antibody is used in flow cytometry, please check FCM antibodies.
Research use only - DownloadInstruction Manual
- CategoryInfection immunityImmune moleculeHematologyPulmonology
- SourcePolyclonal antibody preparation, Host Rabbit
- Ig Type IgG, Potency n/a
- PurificationAntigen-specific affinity chromatography followed by Protein A affinity chromatography
- LabelNone
- Immunogen NPA546Hu01-Native Immunoglobulin A (IgA)
- Buffer Formulation0.01M PBS, pH7.4, containing 0.05% Proclin-300, 50% glycerol.
- TraitsLiquid, Concentration 0.5mg/mL
Sign into your account
Share a new citation as an author
Upload your experimental result
Review

Contact us
Please fill in the blank.
Specifity
The antibody is a rabbit polyclonal antibody raised against IgA. It has been selected for its ability to recognize IgA in immunohistochemical staining and western blotting.
Usage
Western blotting: 0.01-2µg/mL;
Immunohistochemistry: 5-20µg/mL;
Optimal working dilutions must be determined by end user.
Storage
Store at 4°C for frequent use. Stored at -20°C in a manual defrost freezer for two year without detectable loss of activity. Avoid repeated freeze-thaw cycles.
Stability
The thermal stability is described by the loss rate. The loss rate was determined by accelerated thermal degradation test, that is, incubate the protein at 37°C for 48h, and no obvious degradation and precipitation were observed. The loss rate is less than 5% within the expiration date under appropriate storage condition.
Giveaways
Increment services
Citations
- Sequence-Based Typing-Study on the Relationship Between Subclinical Mastitis and BoLA-DRB3.2* Allelic Polymorphism in Egyptian CowsIdosi: Source
- EVALUATION OF PHYSICO-CHEMICAL PROPERTIES OF COLOSTRUM SUPPLEMENTED DAHIIjfans: Source
- Effects of Clostridium butyricum on growth performance, immune function, and cecal microflora in broiler chickens challenged with Escherichia coli K88Pubmed: 24570422
- Specific humoral immune response induced by Propionibacterium acnes can prevent Actinobacillus pleuropneumoniae infection in miceAsm: Source
- Speci?c Humoral Immune Response Induced by Propionibacterium acnes Can Prevent Actinobacillus pleuropneumoniae Infection in MicePubmed:24429068
- Proteomics on porcine haptoglobin and IgG/IgA show protein species distribution and glycosylation pattern to remain similar in PCV2-SD infectionPubmed:24576640
- Dietary squid ink polysaccharide could enhance SIgA secretion in chemotherapeutic micePubmed:25308407
- Oropharyngeal colostrum administration in extremely premature infants: an RCT.Pubmed:25624376
- Fecal microbiota transplantation and bacterial consortium transplantation have comparable effects on the re-establishment of mucosal barrier function in mice with intestinal dysbiosisPubMed: 26217323
- Effects of fermented cottonseed meal on growth performance, serum biochemical parameters, immune functions, antioxidative abilities, and cecal microflora in broilers10.108:09540105.2017.1311308
- SYSTEMISCHE ENTZÜNDUNG BEI CHRONISCHER NIERENINSUFFIZIENZ – DIE ROLLE DER DARMFLORApatent:US9763998B2
- Sub-chronic inhalation of reclaimed water-induced fibrotic lesion in a mouse modelPubmed:29655095
- Recombinant Lactococcus lactis co-expressing OmpH of an M cell-targeting ligand and IBDV-VP2 protein provide immunological protection in chickensPubmed:29289381
- Effects of and on growth performance, immune function and volatile fatty acid level of caecal digesta in broilers10.1080:09540105.2018.1457013
- Effect of Multi-Microbial Probiotic Formulation Bokashi on Pro-and Anti-Inflammatory Cytokines Profile in the Serum, Colostrum and Milk of Sows, and in a …Pubmed:29305686
- Altered immunoglobulins (A and G) in Ghanaian patients with type 2 diabetesPubmed:29623201
- The gut flora modulates intestinal barrier integrity but not progression of chronic kidney disease in hyperoxaluria-related nephrocalcinosisPubmed: 31081025
- Yacon (Smallanthus sonchifolius): Effect on Integrity of Intestinal Barrier, Inflammatory Response and Oxidative Stress in Animal Model of Colon Cancer (P06-052-19)Pubmed: 31225040
- Effects of Paramylon Extracted from Euglena gracilis EOD-1 on Parameters Related to Metabolic Syndrome in Diet-Induced Obese MicePubmed: 31330894
- Effects of polysaccharides from Yingshan Yunwu tea on meat quality, immune status and intestinal microflora in chickensPubmed: 32224178
- Effect Long-Term Exposure to Different Doses of Lipopolysaccharides on the Intestinal Mucosal Immune Barrier
- Effects of chitooligosaccharide supplementation on laying performance, egg quality, blood biochemistry, antioxidant capacity and immunity of laying hens during the …
- Women Scientist Scientist Mentor
- MicroRNA profiling in Chinese children with Henoch©\Schonlein purpura and association between selected microRNAs and inflammatory biomarkers33533510
- Trace endotoxin in reclaimed water is only one of the risk sources in subchronic inhalation exposure34090073
- Monascus ruber fermented Panax ginseng ameliorates lipid metabolism disorders and modulate gut microbiota in rats fed a high-fat diet34098018
- Dietary Supplementation of Inulin Ameliorates Subclinical Mastitis via Regulation of Rumen Microbial Community and Metabolites in Dairy Cows34494854
- Sulfated modification enhances the immunomodulatory effect of Cyclocarya paliurus polysaccharide on cyclophosphamide-induced immunosuppressed mice through …34865774
- Three Urban of China: A Cohort Study of Maternal-Infant Factors and HM Protein ComponentsPubmed:35438093
- The effect of the multi-strain probiotic preparation EM Bokashi® on selected parameters of the cellular immune response in pigs
- Bovine lactoferricin ameliorates intestinal inflammation and mucosal barrier lesions in colitis through NF-κB/NLRP3 signaling pathways
- Salivary IgA Depression in Drug-Influenced Gingival Enlargement among Hypertensive Patients